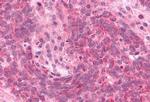
DUSP26 Antibody in Immunohistochemistry (Paraffin) (IHC (P))

Search
Invitrogen
DUSP26 Polyclonal Antibody
{{$productOrderCtrl.translations['antibody.pdp.commerceCard.promotion.promotions']}}
{{$productOrderCtrl.translations['antibody.pdp.commerceCard.promotion.viewpromo']}}
{{$productOrderCtrl.translations['antibody.pdp.commerceCard.promotion.promocode']}}: {{promo.promoCode}} {{promo.promoTitle}} {{promo.promoDescription}}. {{$productOrderCtrl.translations['antibody.pdp.commerceCard.promotion.learnmore']}}
产品信息
PA1-32629
宿主/亚型
分类
类型
抗原
偶联物
形式
浓度
规格
保存条件
运输条件
RRID
产品详细信息
PA1-32629 detects DUSP26 from human samples.
靶标信息
This gene encodes a member of the tyrosine phosphatase family of proteins and exhibits dual specificity by dephosphorylating tyrosine as well as serine and threonine residues. This gene has been described as both a tumor suppressor and an oncogene depending on the cellular context. This protein may regulate neuronal proliferation and has been implicated in the progression of glioblastoma through its ability to dephosphorylate the p53 tumor suppressor. Alternative splicing results in multiple transcript variants. [provided by RefSeq, Feb 2015].
仅用于科研。不用于诊断过程。未经明确授权不得转售。